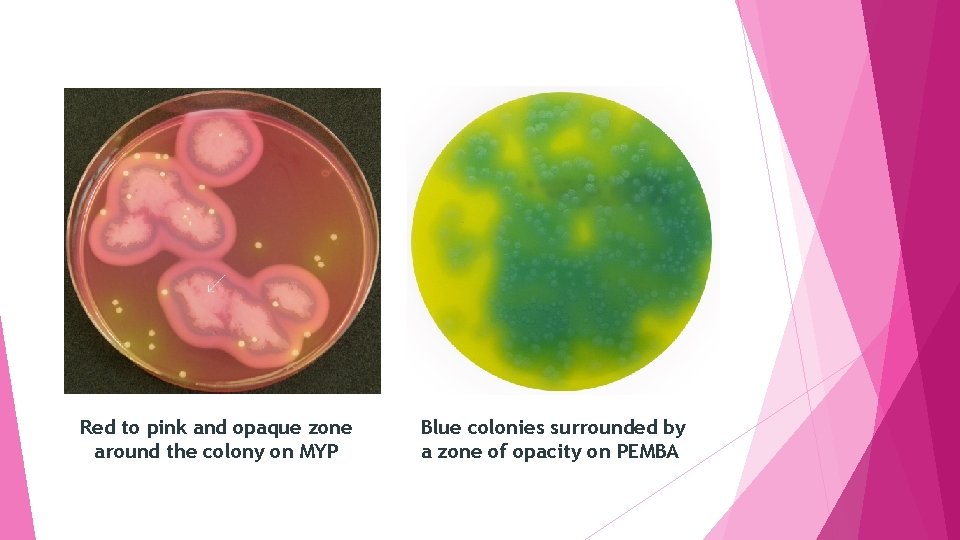
Red to pink and opaque zone around the colony on MYP Blue colonies surrounded
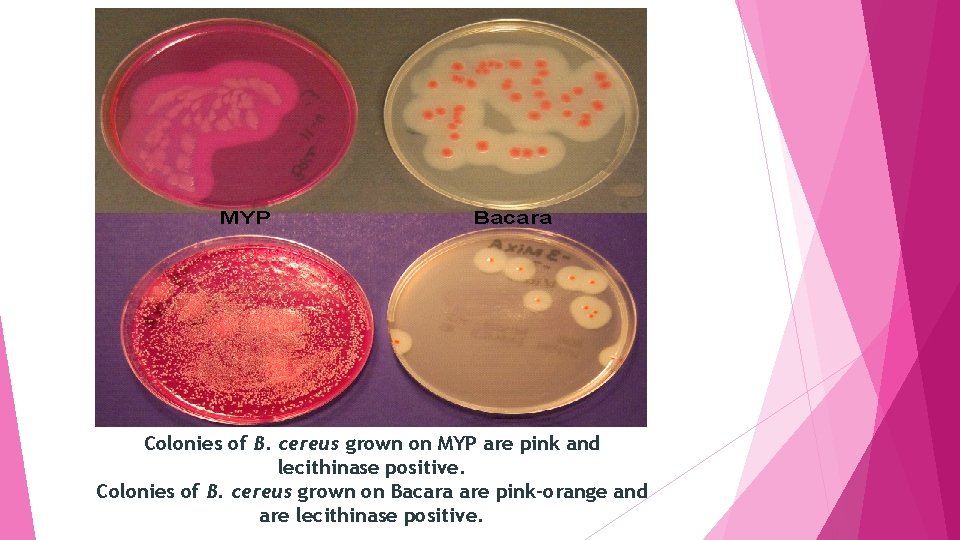
Colonies of B. cereus grown on MYP are pink and lecithinase positive. Colonies of

Enumeration of Bacillus Cereus in Foods General Characteristics

Enumeration of Bacillus Cereus in Foods

General Characteristics Gram‐positive rod Spore‐forming Motile Aerobic to facultative anaerobic( aerobic ally growing are less resistant to heat and acid than B. cereus cells grown anaerobically). When grown under aerobic conditions on 5% sheep blood agar at 37 ºC, B. cereus colonies are dull, grey and opaque with arough matted surface Beta hemolytic bacteria. Commonly found in soil and food. Bacillus cereus is becoming one of the more important causes of food poisoning. B. cereus is easily spread from its natural environment to many types of foods, especially of plant origin Its spores and vegetative forms are frequent inhabitants of many food types, especially cereals and its derivatives, rice, vegetables, spices, herbs and additives. These forms are also present in milk and dairy products, raw meat, eggs, and processed foods as well as in ready to eat food stuffs.

B. cereus can grow well after cooking and cooling (<48 ºC). B. cereus food poisoning may occur when foods are prepared and held without adequate refrigeration for several hours before serving, with B. cereus reaching >106 cells/g. The primary mode of transmission is via ingestion of B. cereus contaminated food. There are two types of B. cereus food poisoning(self limiting): The first type, caused by an emetic toxin which produced by growing cells in the food and results in vomiting The second type, caused by enterotoxins which produced during vegetative growth of B. cereus in the small intestine and gives diarrhoea Emetic type of food poisoning has been largely associated with the consumption of rice and pasta, while the diarrheal type is transmitted mostly by milk products, vegetables and meat The total infective dose seems to vary between about 105 and 108 viable cells or spores. Thus any food containing more than 104 cells/gram cannot be completely safe for consumption.

B. cereus spores are extremely heat resistant, so while cooking at proper temperatures would destroy most foodborne pathogens including the vegetative cells of B. cereus, it does not destroy the spores. However, Formaldehyde, Chlorine, Iodine, Acids, Alkalis, H 2 O 2, Peroxy acids, Ozone are all sporicidal at high concentrations with long contact times. Rapid cooling and proper reheating of cooked food are very essential if the food is not consumed immediately. Long‐term storage must be at temperatures below 8 °C (or preferably 4– 6 °C to prevent growth of B. cereus). Low p. H foods (p. H 4. 3) can be considered safe from growth of the food‐ poisoning Bacillus spp. B. cereus is biochemically identical to B. thuringiensis are closely related and genomic studies have proposed that they should be merged into a single species. B. thuringiensis is used worldwide as a biological insecticide due to the production of crystal proteins with highly specific activity against certain insects.

Isolation and identification of B. cereus There are two differential media in common use: Mannitol–egg yolk–polymyxin agar (MYPA) Polymyxin Pyruvate Egg‐Yolk Mannitol Bromothymol Blue Agar (PEMBA) Also, chomogenic media including Bacara agar and Brilliance. TM Bacillus cereus agar can be used. Mannitol–egg yolk–polymyxin agar(MYP agar) § The standard media for plating B. cereus § It has little selectivity so background flora is not inhibited and can mask the presence of B. cereus. § Polymyxin B is used as the primary selective agent for the B. cereus group(resistanceto polymyxin) § B. cereus does not ferment mannitol but does produce phosphatidylcholine‐preferring phospholipase C (lecithinase). § Colonies of B. cereus grown on MYP are pink and lecithinase positive.

Polymyxin Pyruvate Egg-Yolk Mannitol Bromothymol Blue Agar (PEMBA) § B. cereus forms crenated blue colonies surrounded by a zone of opacity in the medium Brilliance Bacillus cereus Agar (formerly Chromogenic Bacillus cereus Agar) § A chromogenic medium for the isolation and differentiation of Bacillus cereus from food samples. § Polymixin B inhibits most Gram‐negative organisms and some Gram‐positive organisms including some Bacillus other than Bacillus cereus. § Trimethoprim, is active against many Gram‐positive bacteria including Staphylococcus aureus, Enterococcus spp. § Colonies of B. cereus are blue to green colonies.

Bacara agr(Bacillus Chromogenic Media) § A chromogenic selective and differential agar that promotes the growth and identification of B. cereus, but inhibits the growth of background flora. § Colonies of B. cereus grown on Bacara are pink‐orange and are lecithinase positive. Confirmation of B. cereus involves a battery of biochemical tests.
Red to pink and opaque zone around the colony on MYP Blue colonies surrounded by a zone of opacity on PEMBA

Blue to green colonies on Brilliance Bacillus cereus Agar pink-orange and opaque zone around the colony on Bacara agar

Enumeration of B. cereus in food The B. cereus count is determined by culture techniques using the spread plate method with agar plates that are selective for B. cereus, followed by biochemical identification techniques. The unsatisfactory level for B. cereus in food is ≥ 104 CFU/gram (potentially hazardous).

Sample preparation Using aseptic technique, weigh 50 g of sample into sterile blender jar. Add 450 m. L phosphate‐buffered dilution water (1: 10 dilution) and blend the sample with dileunt. Prepare serial dilutions from 10‐ 2 to 10‐ 6 by transferring 1 m. L homogenized sample (1: 10 dilution) to 9 m. L dilution blank, mixing well with vigorous shaking, and continuing until 10‐ 6 dilution is reached. Plate count of B. cereus Inoculate duplicate Bacara or MYP agar plates with each dilution of sample (including 1: 10) by spreading 0. 1 m. L evenly onto surface of each plate with sterile glass spreading rod. Incubate plates 18‐ 24 h at 30°C Observe for colonies surrounded by precipitate zone, which indicates that lecithinase is produced. B. cereus colonies are usually a pink‐orange color on Bacara or pink on MYP and may become more intense after additional incubation.

If reactions are not clear, incubate plates for additional 24 h before counting colonies. Calculate number of B. cereus cells/g of sample. This is the presumptive plate count of B. cereus. Pick colonies from the Bacara or MYP plates and transfer one colony to BHI with 0. 1% glucose for enterotoxin studies and a nutrient agar slant for storage. Typical colonies grown on Bacara or MYP must be confirmed with biochemical testing.
Colonies of B. cereus grown on MYP are pink and lecithinase positive. Colonies of B. cereus grown on Bacara are pink-orange and are lecithinase positive.

Most probable number (MPN) of B. cereus The most probable number (MPN) method is recommended for routine surveillance of products in which small numbers of B. cereus are expected. This method is also effective in testing foods that may contain a large population of competing species or in dehydrated food products in which the potential spores would outnumber vegetative cells and require additional nutrients to germinate. Inoculate 3‐tube MPN series in trypticase soy‐polymyxin broth, using 1 m. L inoculum of 10‐ 1, 10‐ 2, and 10‐ 3 dilutions of sample with 3 tubes at each dilution. (Additional dilutions should also be tested if B. cereus population is expected to exceed 103/g. ) Incubate tubes 48 ± 2 h at 30 + 2°C and observe for turbid growth, which is typical of B. cereus. Streak cultures from turbid, positive tubes onto separate agar plates (either Bacara or MYP) and incubate plates 18‐ 24 h at 30°C.

Pick one or more pink‐orange (Bacara) or pink (MYP), lecithinase‐positive colonies from each agar plate and transfer to BHI with 0. 1% glucose for enterotoxin studies and nutrient agar slants for storage. Typical colonies grown on Bacara or MYP must be confirmed with biochemical testing. Calculate MPN of B. cereus cells/g of sample based on the number of tubes at each dilution in which the presence of B. cereus was confirmed. Biochemical testing will be necessary to delineate to the species level, however, enterotoxins can be carried by Bacillus spp. other than B. cereus.

Confirmation of B. cereus Gram‐stained smears from slants and examine microscopically. B. cereus will appear as large Gram‐positive bacilli in short‐to‐long chains; spores are ellipsoidal, central to subterminal, and do not swell the sporangium. Transfer loopful of culture from each slant to tube containing 0. 5 ml of sterile phosphate‐buffered dilution water with Vortex mixer and following confirmatory media: 1. Phenol red glucose broth: § Incubate tubes anaerobically 24 h at 35°C. Positive result is indicated by increased turbidity and color change from red to yellow for B. cerues. 2. Nitrate broth 3. Modified VP medium § Test is positive if pink or violet color develops.

4. Tyrosine agar slant. 5. Lysozyme broth. § 6. Inoculate 2. 5 ml of nutrient broth containing 0. 001% lysozyme. MYP agar. § This test may be omitted if primary inoculation media was Bacara or test results were clear‐cut with original MYP agar plates and there was no interference from other microorganisms. B. cereus colonies are pink and usually lecithinase‐positive and mannitol‐negative on MYP agar.

- Slides: 18